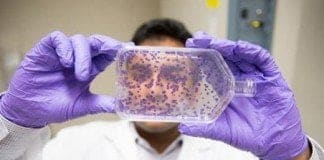
İmmunoterapi kemoterapiye alternatif mi ?

Genler bozulunca kanser oluşuyor
Türk Tıbbi Onkoloji Derneği’nin 6. Kongresine katılan Prof. Yosef Yarden kanserin oluşum nedenleri konusunda açıklamalarda bulundu.
Nadiren doğumsal bazı bozuk genler çocukluk çağı kanserlerine yol...
Alzheimer da implantı tedavi araştırmaları
Değerli okuyucularımız bu henüz araştırma safhasında bir tedavidir eğer etkinliği saptanırsa tıpta uygulanabilir hale geçmesi için en az 5 sene geçmesi gerekebiliyor bilgilerinize sunarız.
İsviçre'li...
İmmunoterapi kemoterapiye alternatif mi ?
NTV.com.tr de yer alan haberde Prof. Dr. Gökhan Demir tarafından immunoterapi ile kemoterapi karşılaştırılıyor :
Kemoterapi kanserle savaşta halihazırda en önemli silah ancak son yıllarda...
Diş Fırçası Kullanımı
Sağlıklı diş ve diş etlerine sahip olmak, herkesin için oldukça önem teşkil eder. Diş ve ağız sağlığını korumak adına farkında olunmadan çeşitli hatalar yapılabilir....
Emziren annenin göğüs bakımı
Özellikle emzirme sırasında göğüs çatlakları ve hatta bunlardan meydana gelen enfeksiyonlarla sıklıkla karşılaşabiliyoruz. Emziren annelere ilk önerim mutlaka doğru şekilde emzirme eğitimini almalarıdır.
Emzirme anne...
Vücut Kokusu
Vücut kokumuz nasıl oluşur ?
Vücudumuz 2 ila 5 milyon arasında ter bezine sahiptir. Terin kendisi ki biz onun vücut kokusundan sorumlu olduğunu varsayarız, tek...
Hırsızlık Hastalığı ( Kleptomani )
Kleptomani Nedir ?
İhtiyacı olmadığı, hemen kullanmayacağı halde ve maddi değeri nedeniyle satma düşüncesi olmadan bir takım nesneleri izinsiz olarak alarak, onlara sahip olma şeklinde...
Sıcak ve soğuk çarpmalarında ilk yardım
Normal vücut ısısı 36 - 37 °C dir. Ancak vücut başa çıkabileceğinden fazla sıcağa maruz kalırsa sıcak krampları, sıcak bitkinliği ve sıcak çarpması gibi ya da tam tersi aşırı soğuğa maruz kalırsa kısmi veya tam donma gibi sorunlar görülebilir.